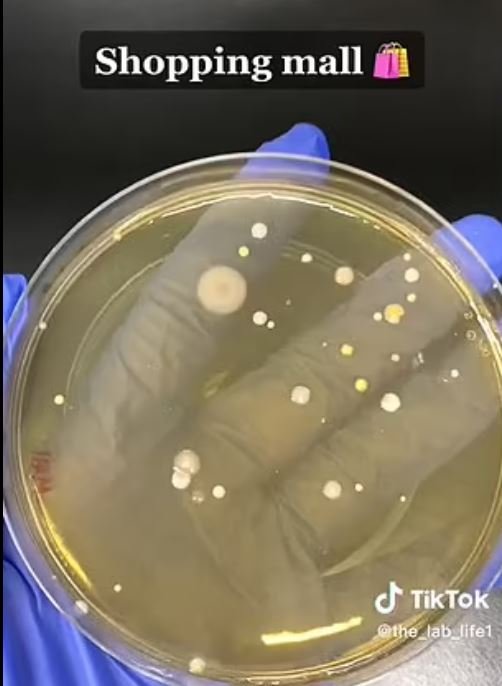
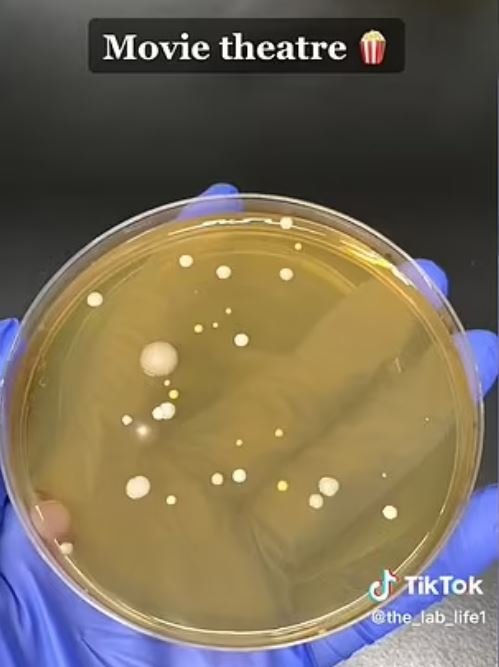

The_lab_life isimli TikTok kullanıcısı, el kurutma makinelerinin havadaki bakterileri nasıl emdiğini ve yeni yıkanmış ellere püskürttüğünü gösterdi.
TikTok kullanıcısı öğrenci; alışveriş merkezi, sinema ve iş yerindeki tuvaletlerden aldığı örnekleri inceledi. Örnekleri inkübe ettikten sonra, üçünün de organizmalar içerdiğini keşfetti.
Alışveriş merkezinden alınan örnek
Alışveriş merkezinden alınan örnekBunun nedeni ise, makinelerin bakterilerle dolu olması değil, el kurutma makinelerinin banyodaki bakteriyel aerosolleri ellere püskürtmesi. Laboratuvar öğrencisi hangi bakterilerin yakalandığını açıklamasa da önceki araştırmalar E. coli, hepatit ve dışkı bakterilerinin umumi tuvaletlerde bulunduğunu gösteriyordu.
Videodaki deneyde; iş yerinden alınan örneğin en çok bakteriye sahip olduğu görüldü. TikTok kullanıcısı, mikropların içeriğini belirtmese de 2015 yılında yapılan bir araştırmada, umumi tuvaletlerde 77 binden fazla farklı bakteri ve virüs türüne ait genetik izler bulunmuştu. Ve güçlü bir el kurutma makinesi kullanıldığında bu bakteriler yüzeylerden kalkıp ellere püskürtülür.
Sinema salonlarının tuvaletlerinden alınan örnek.
Sinema salonlarının tuvaletlerinden alınan örnek.Ayrıca başka bir araştırmada da kurutucularla mikropların en büyük dağılımının, yerden 0,6 – 0,9 metre yükseklikte olduğu bulundu; bu da kurutucunun yanında duran küçük çocukların tam yüz hizasına denk geliyor.
Westminester Üniversitesi'nden baş araştırmacı Dr Keith Redway şunları söyledi: "Bu bulgular, tek kullanımlık havluların tüm el kurutma yöntemleri arasında en az mikrop yayan olduğunu açıkça gösteriyor."

































